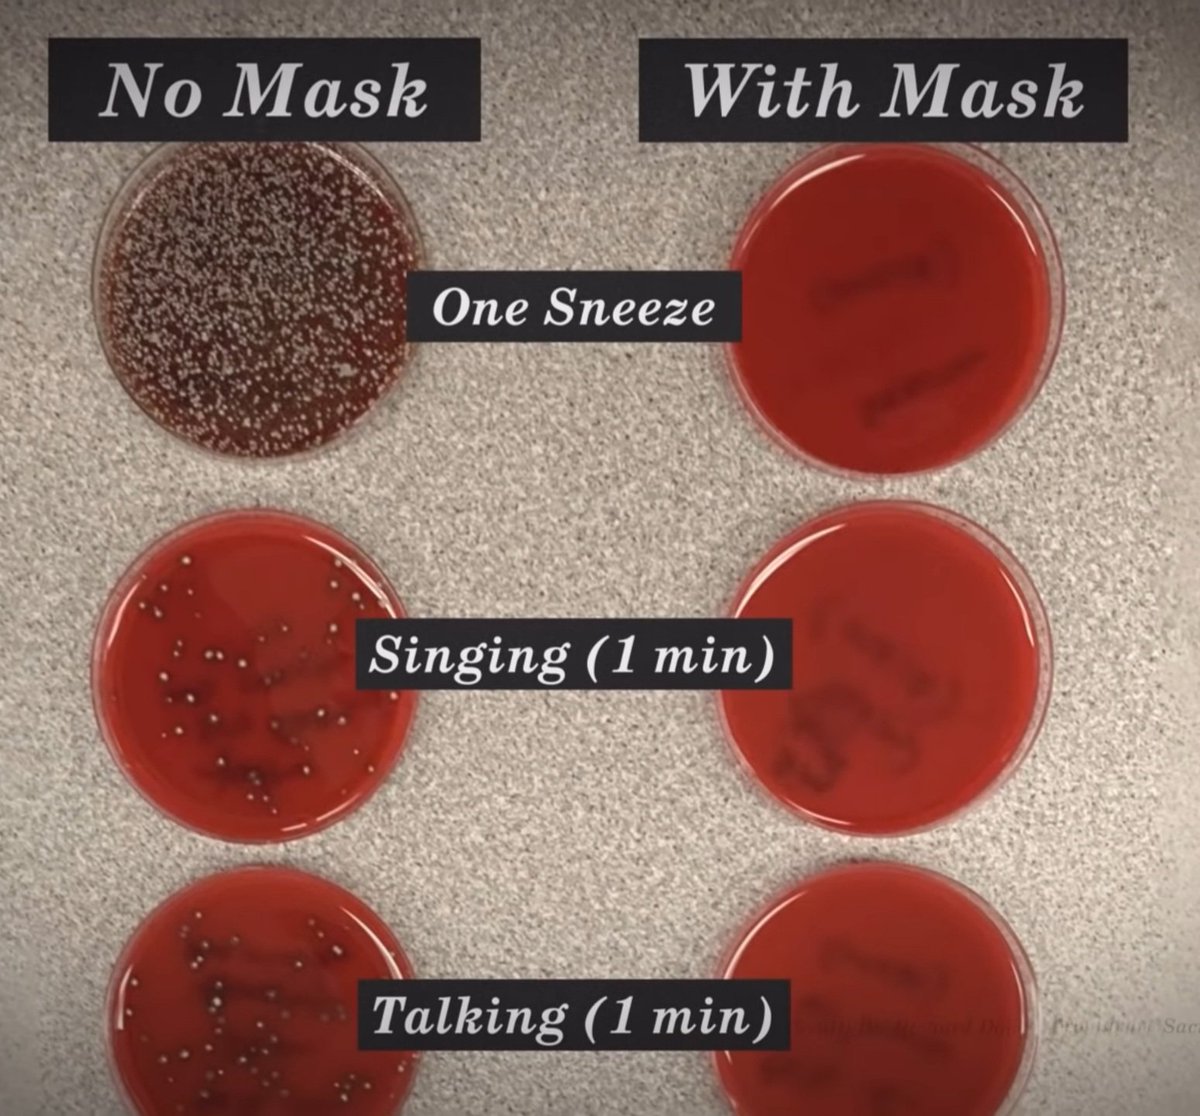
Literally a breathing petri dish... #COVID19

Jason Ki
@jasonki1990
About me at Jasonjki.github.io
ID: 882076144278884353
04-07-2017 03:18:35
68 Tweet
138 Followers
115 Following






Using the encoding-decoding modeling approach to investigate the strength of visual response during Mario Kart videogame. Check out the new publication. @lucas_c_parra Jacek Dmochowski CCNY Neural Engineering Lab researchgate.net/publication/34…